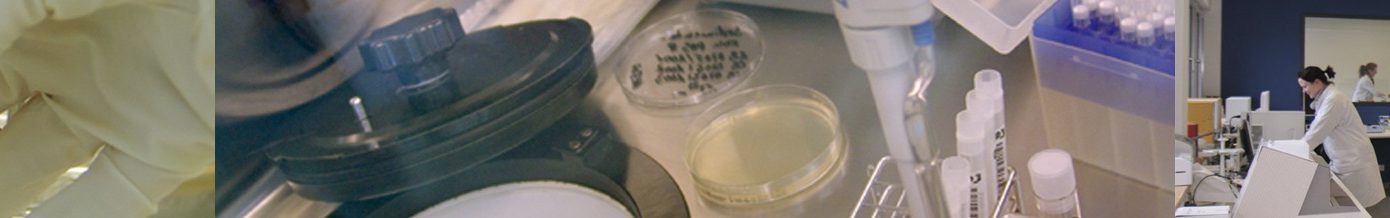
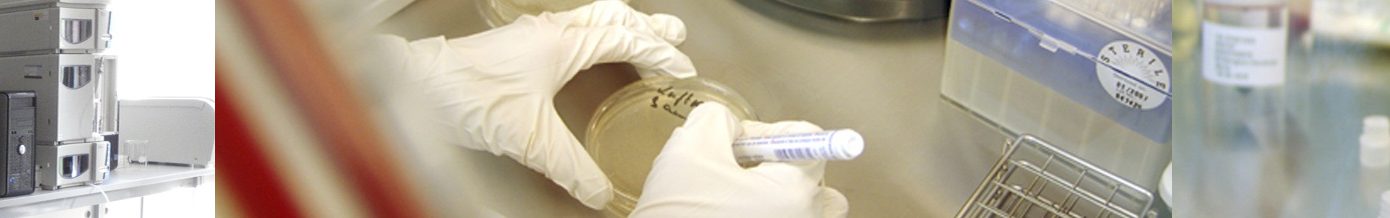

El grupo MLB está integrado por “Stem Cell”, “Medizinische Laboratorien Bonn” (MLB), y “Centrum für Blutgerinnungsstörungen und Transfusionsmedizin” (CBT), especializados en la conservación de progenitores hematopoyéticos – cordón umbilical, médula ósea y sangre periférica – y la medicina de trasfusión sanguínea, entre otros.
STEMCELL
Stem Cell es una empresa biotecnológica pionera en España en el ámbito del procesado y la conservación de células madre del cordón umbilical para uso autólogo.
Stem Cell procesa bajo la dirección técnica y protocolos de trabajo de MLB y la experiencia de CBT en el tratamiento de la sangre. Esto nos permite ofrecer un servicio global en un entorno regulado, con el apoyo de un exclusivo equipo médico y una infraestructura especializada en el tratamiento de muchas patologías relacionadas con la sangre.
Íntimamente relacionada con Medizinische Laboratorien Bonn (MLB) y CBT, importante grupo sanitario con laboratorios en Alemania, Stem Cell dispone hoy de un laboratorio con las más avanzadas instalaciones propias en España, lo que permite ofrecer más y mejores servicios al mejor precio.

LABORATORIO PROPIO EN ESPAÑA
Stem Cell localiza su laboratorio en el Parque Tecnológico de Boecillo, en Valladolid. En un entorno asociado a la biotecnología, donde disponemos de instalaciones y equipamientos de última generación, con capacidad de recepción 7 días / 24 hrs.

MLB GmbH
Medizinische Laboratorien Bonn (MLB) es el lugar de almacenaje definitivo de las muestras procesadas en España. Está dedicado al aislamiento y almacenaje de células madre procedentes de la sangre del cordón umbilical y la médula ósea. Sus instalaciones cuentan con Sala Blanca y las mayores exigencias de trabajo, que también afectan a todas las fases desarrolladas en el laboratorio español: recogida, procesado y criopreservación.
MLB es una sección del prestigioso CBT, centro médico especializado en la diagnosis y tratamiento de trastornos de la sangre y medicina trasfusional. El centro es banco de sangre y centro de referencia en medicina de trasfusión en la región alemana de Renania del Norte - Westfalia.

CBT - Centro de Trastornos hemorrágicos y medicina de transfusión
Diagnóstico y tratamiento de enfermedades del sistema arterial
CBT cuenta con un Consejo Médico integrado por científicos y médicos clínicos con éxito en el campo de los desórdenes de la sangre y terapia celular. Este consejo actúa como asesor en todos los asuntos concernientes a la recolección, procesado, testado, almacenado y liberación de células madre adultas aisladas del cordón umbilical o médula ósea.